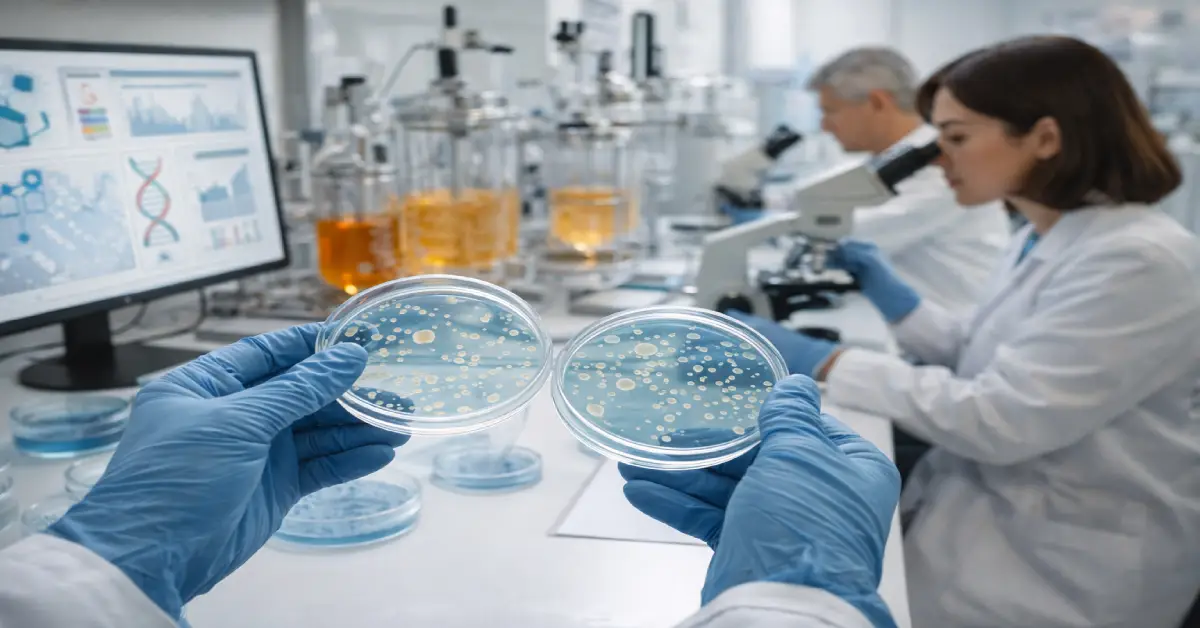
فرآیند علمی و واقعی کار با پروبیوتیکها در بیوتکنولوژی غذا

۷ واقعیت کلیدی درباره پروبیوتیک مواد غذایی | آینده بیوتکنولوژی غذا

پروبیوتیک مواد غذایی به مجموعهای از میکروارگانیسمهای زنده گفته میشود که در صورت مصرف به مقدار مناسب، میتوانند عملکرد زیستی بدن را بهبود دهند و همزمان مسیر توسعه بیوتکنولوژی غذا را متحول کنند. این ترکیبات دیگر فقط یک افزودنی ساده نیستند، بلکه به یکی از پایههای علمی طراحی غذاهای آینده تبدیل شدهاند.
اما این موضوع بسیار عمیقتر از تعریف کوتاه بالا است. در ادامه، نقش پروبیوتیکها را از منظر علمی، فناورانه و آیندهمحور بررسی میکنیم تا روشن شود چرا بیوتکنولوژی غذا بدون آنها قابل تصور نیست.
در ادامه، موضوع را مرحلهبهمرحله و بر اساس شواهد علمی بررسی میکنیم.
پروبیوتیک مواد غذایی چیست و چرا اهمیت دارد؟
پروبیوتیکها میکروارگانیسمهایی زنده هستند که بهصورت هدفمند به مواد غذایی افزوده میشوند تا پس از مصرف، اثرات زیستی مفیدی ایجاد کنند. نکته مهم این است که این اثرات وابسته به زندهماندن میکروارگانیسم تا زمان مصرف و رسیدن به محل اثر است.
اهمیت پروبیوتیکها فقط به سلامت فردی محدود نمیشود. این ترکیبات:
- الگوی طراحی غذا را تغییر دادهاند
- مفهوم «غذای عملکردی» را شکل دادهاند
- مرز بین غذا و علم زیستی را کمرنگ کردهاند
در بیوتکنولوژی غذا، پروبیوتیکها بهعنوان واحدهای زنده مهندسیشده شناخته میشوند که باید هم از نظر زیستی پایدار باشند و هم از نظر صنعتی قابل تولید.
برای درک بهتر نقش پروبیوتیکها در سلامت و عملکرد سیستم گوارشی، میتوانید مقاله خواص پروبیوتیک برای بهبود عملکرد بدن را نیز مطالعه کنید.
نقش بیوتکنولوژی در توسعه پروبیوتیک مواد غذایی
بیوتکنولوژی غذا بستری است که امکان شناسایی، بهینهسازی و کنترل دقیق پروبیوتیکها را فراهم میکند. بدون ابزارهای زیستفناورانه، تولید پایدار این ترکیبات عملاً غیرممکن است.
| چالش در تولید پروبیوتیک | نقش بیوتکنولوژی غذا |
|---|---|
| شناسایی سویههای مؤثر | غربالگری زیستی و ژنتیکی سویهها |
| تفاوت عملکرد بین سویهها | انتخاب هدفمند بر اساس عملکرد زیستی |
| ناپایداری در فرآوری صنعتی | بهینهسازی شرایط تخمیر |
| کاهش زندهمانی در محصول | استفاده از ریزپوشانی زیستی |
| افت کیفیت در زمان نگهداری | پایش زیستی و کنترل شرایط محیطی |
| نیاز به ایمنی بالا | ارزیابی ایمنی و استانداردسازی |
درباره کاربرد خدمات بیوتکنولوژی و استانداردهای آزمایشگاهی در این حوزه، میتوانید بخش آزمایشگاه بیوتکنولوژی را ببینید.
انتخاب سویههای هدفمند
هر پروبیوتیک اثر یکسانی ندارد. تفاوت سویهها باعث تفاوت در:
- پایداری حرارتی
- تحمل اسیدی
- تعامل با سیستم زیستی بدن
بیوتکنولوژی امکان غربالگری علمی و انتخاب سویههایی را میدهد که دقیقاً برای یک کاربرد غذایی مشخص مناسب هستند.
بهینهسازی شرایط رشد
برای تولید صنعتی پروبیوتیک مواد غذایی، شرایط تخمیر باید کاملاً کنترلشده باشد. پارامترهایی مانند:
- دما
- pH
- منبع تغذیه
- زمان رشد
همگی به کمک فناوریهای زیستی تنظیم میشوند تا حداکثر کارایی زیستی حفظ شود.
چالش زندهمانی پروبیوتیکها در مواد غذایی
یکی از مهمترین چالشها، حفظ زندهمانی پروبیوتیکها از خط تولید تا زمان مصرف است. بسیاری از عوامل محیطی میتوانند باعث کاهش اثربخشی آنها شوند.
مهمترین عوامل مخرب عبارتاند از:
- حرارت فرآیند
- اکسیژن
- رطوبت
- زمان نگهداری
برای حل این مشکل، بیوتکنولوژی غذا از روشهایی مانند ریزپوشانی زیستی (Microencapsulation) استفاده میکند که باعث محافظت فیزیکی از میکروارگانیسمها میشود، بدون اینکه عملکرد آنها مختل شود.

پروبیوتیک مواد غذایی و تحول مفهوم غذای عملکردی
غذای عملکردی دیگر فقط یک اصطلاح بازاری نیست. این مفهوم بر پایه شواهد زیستی و عملکرد قابل اندازهگیری شکل گرفته است. پروبیوتیکها نقش مرکزی در این تحول دارند.
ویژگیهای غذاهای حاوی پروبیوتیک:
- اثر زیستی فراتر از تأمین انرژی
- طراحی هدفمند برای عملکرد مشخص
- ارتباط مستقیم با علوم زیستی
در واقع، بیوتکنولوژی غذا به کمک پروبیوتیکها غذا را از یک محصول مصرفی ساده به یک سامانه زیستی فعال تبدیل کرده است.
آینده مهندسیشده پروبیوتیکها در صنعت غذا
مسیر آینده به سمت پروبیوتیکهایی حرکت میکند که:
- اختصاصی طراحی میشوند
- عملکرد مشخص و قابل پیشبینی دارند
- با ماتریس غذایی سازگار هستند
در این رویکرد، پروبیوتیک دیگر بهصورت تصادفی انتخاب نمیشود، بلکه بر اساس هدف زیستی، نوع محصول و شرایط مصرف طراحی میشود.
همافزایی با فناوریهای نوین
پیشرفتهایی مانند زیستفناوری دقیق (Precision Biotechnology) امکان تولید نسل جدیدی از پروبیوتیکها را فراهم کرده است که:
- پایداری بالاتری دارند
- سازگاری بهتری با فرآوری صنعتی نشان میدهند
- اثربخشی زیستی قابلاعتمادتری دارند

ملاحظات ایمنی و استانداردسازی
با افزایش نقش پروبیوتیک مواد غذایی، مسئله ایمنی اهمیت دوچندان پیدا میکند. هر سویه باید:
- از نظر زیستی ایمن باشد
- اثرات جانبی ناخواسته نداشته باشد
- در چارچوب استانداردهای بینالمللی ارزیابی شود
بیوتکنولوژی غذا ابزارهای لازم برای ردیابی، کنترل و تضمین ایمنی این میکروارگانیسمها را فراهم میکند.
⚠️ از منظر کیفیت و ایمنی زنجیره غذایی، خواندن مقاله اندازهگیری مایکوتوکسین در مواد غذایی چگونه انجام میشود میتواند دید کاربردیتری بدهد.
چرا پروبیوتیکها قلب آینده بیوتکنولوژی غذا هستند؟
بیوتکنولوژی غذا به دنبال تولید محصولاتی است که:
- هوشمند باشند
- عملکرد مشخص داشته باشند
- با بدن انسان تعامل فعال برقرار کنند
پروبیوتیکها دقیقاً در مرکز این رویکرد قرار دارند. آنها تنها ترکیبات غذایی هستند که زندهاند، واکنش نشان میدهند و اثر میگذارند. به همین دلیل، آینده این صنعت بدون آنها قابل تصور نیست.
نگاهی ماندگار به مسیر پیش رو
پروبیوتیکها نشان دادهاند که غذا میتواند چیزی فراتر از یک منبع انرژی باشد. با تکیه بر بیوتکنولوژی، این ترکیبات به ابزارهایی علمی برای طراحی نسل جدید غذا تبدیل شدهاند. درک درست این مسیر، کلید فهم آینده صنعت غذا است؛ آیندهای که در آن مرز بین زیستشناسی و تغذیه تقریباً از بین میرود.
❓ سوالات متداول درباره پروبیوتیکها
1️⃣ پروبیوتیک مواد غذایی دقیقاً چه تفاوتی با مکملها دارد؟
پروبیوتیکهای غذایی مستقیماً در ماتریس غذا حضور دارند و اثر آنها به نحوه فرآوری و مصرف وابسته است، در حالی که مکملها ساختار جداگانهای دارند.
2️⃣ آیا همه غذاهای تخمیری پروبیوتیک محسوب میشوند؟
خیر. فقط محصولاتی که حاوی میکروارگانیسم زنده با اثر زیستی اثباتشده باشند، در این دسته قرار میگیرند.
3️⃣ چرا زندهمانی پروبیوتیکها اهمیت دارد؟
اگر میکروارگانیسم زنده نماند، اثر زیستی مورد انتظار ایجاد نمیشود و عملکرد محصول از بین میرود.
4️⃣ بیوتکنولوژی چگونه به توسعه پروبیوتیک مواد غذایی کمک میکند؟
از طریق انتخاب سویه، کنترل تخمیر، افزایش پایداری و تضمین ایمنی زیستی.
5️⃣ آینده پروبیوتیکها به کدام سمت حرکت میکند؟
به سمت طراحی هدفمند، عملکرد قابل پیشبینی و سازگاری کامل با فرآیندهای صنعتی و زیستی.
جمعبندی: وقتی علم، غذا را به گفتوگو دعوت میکند
پروبیوتیکها فقط یک روند زودگذر در صنعت غذا نیستند؛ آنها نشانهای روشن از آیندهای هستند که در آن علم، تغذیه و فناوری در کنار هم معنا پیدا میکنند. هرچه شناخت ما از پروبیوتیک مواد غذایی عمیقتر میشود، نیاز به تحلیل دقیقتر، نگاه تخصصیتر و گفتوگوی علمی شفاف نیز پررنگتر خواهد شد. مسیر بیوتکنولوژی غذا مسیری یکطرفه نیست؛ مسیری است مبتنی بر تبادل دانش، پرسشهای هوشمندانه و تصمیمهای آگاهانه. اگر این نگاه علمی برای شما الهامبخش بوده، یعنی در حال حرکت در همان مسیری هستید که آینده این صنعت را شکل میدهد.

